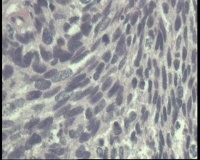

| 图片: | |
|---|---|
| 名称: | |
| 描述: | |
- 请老师看看,宫颈LEEP刀标本怎样报?
| 性别 | 女 | 年龄 | 43岁 | 临床诊断 | 宫颈CINII |
|---|---|---|---|---|---|
| 一般病史 | 我院TCT筛查:ASC—H,在上级医院阴道镜活检CIN II,患者HPV16(+),来我院做LEEP到手术 | ||||
| 标本名称 | 宫颈LEEP标本 | ||||
| 大体所见 | 送检环形组织2.0x1.0x(0.2—0.4)厘米 | ||||
标签:
×参考诊断